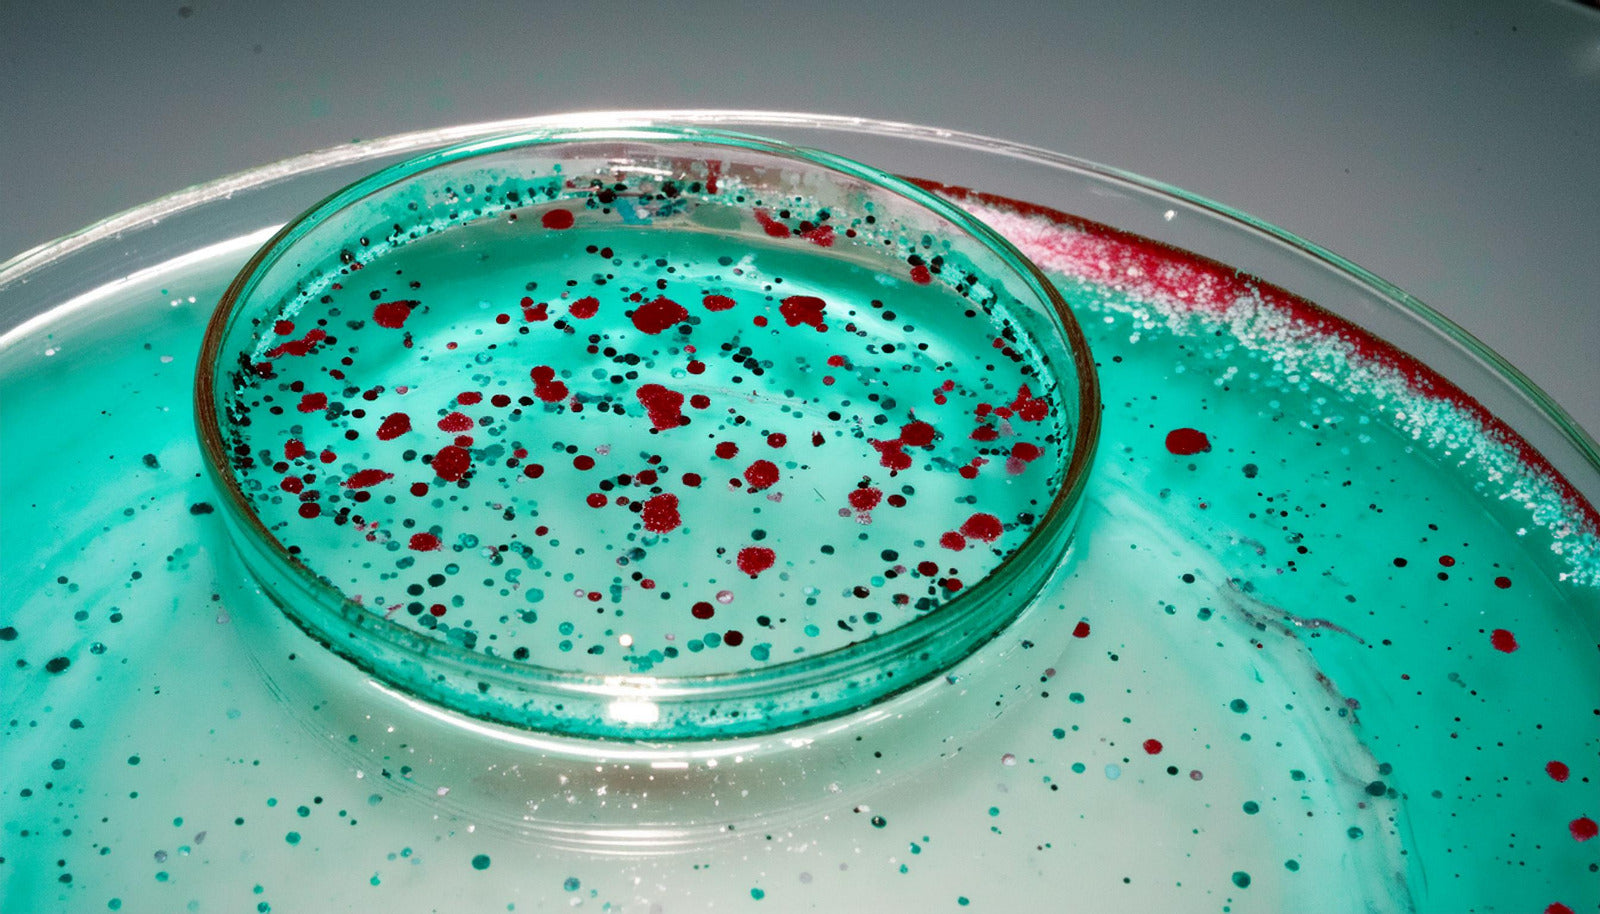

Microplastics - The surprising ingredient your favourite beauty brands are hiding from you.
Are you unknowingly applying plastic to your face? Let’s find out.
Before you start reading this blog, I was hoping you could grab your favourite skincare product and go through its ingredient list. Do you spot acrylates, terms initiating with 'poly'? Yes. Drummmm rolls, please!! You've been putting plastic on your skin. I'm not the one claiming it but, a report by the Plastic Soup Foundation (PSF) having analyzed more than 7,704 beauty and skincare products from major brands does (van Wering, 2022).
According to PSF, 9 out of every 10 beauty products contain Microplastics! But plastic in skincare is unheard of. Right? Wrong! We all have just been unaware of it. Microplastics have been used in skincare since the early 1900s for various reasons we'll discuss later. First, let me tell you what they are.
Microplastics 101- let's get started.
What are microplastics?
As per the European Chemicals Agency (ECHA), microplastics are solid-state synthetic microparticles composed of insoluble, non-biodegradable polymers and functional additives smaller than 5 mm (Microplastics - ECHA, n.d.). Too scientific? Simply put, microplastics are extremely tiny plastic particles, sometimes invisible to the naked eye. Chemically, microplastics are found both in solid and liquid form. They are not just beads found in exfoliating products but, can also be found seamlessly blended in a moisturizer. Hence, they are difficult to detect in your favourite everyday product but, I know you are smart and want a solution. So here's how you can find them. Thank me later ;)
But how do I know if my favourite product contains Microplastics?
The most common way is to check out the ingredient list displayed on the packaging and look for ingredients such as polyethylene, polypropylene, and polymathy methacrylate or check out a list provided by Beat the Microbeads (Guide to Microplastics - Check Your Products, n.d.). However, it isn't sufficient, as the ingredient lists only mention the name and not its physical form. Yes, it's a little complex. Sorryyy.
Moreover, it is worth noting that all microplastics are polymers but, not all polymers are microplastics (Read that again). Hence, a product can have a polymer that could be considered a microplastic but, until one finds out the physical state of the polymer, it cannot be claimed as a microplastic.
What's the use of plastic in skincare?
Who knew today the fight isn't just about reducing plastic in packaging but, removing it from the product as well? A normal consumer can never think of their favorite skin or beauty care products having plastic. However, since we now know that they are widely present, a question arises - What is the use? There must be reasons for these formulations. Well, yes you are right!
- Inexpensive - Plastic is CHEAP! Major brands add them to their low-cost products to prevent an emulsion from separating.
- Texture - Do you wanna get the desired texture? Add some plastic (that's what manufacturers do). They can be used as beads or help give the product that gel-like smooth texture.
- Stabiliser - They are chemically and physically inert, making them unreactive to other ingredients and safe to use.
Microplastics are harmful! (I know, you know it now)
Think about eating plastic. You would never do it, right? ( Right???) However, your body indirectly might be consuming it through food and, now skincare too. This is alarming! Research has evidence, that these tiny particles or polymers can infiltrate our body (Carrington, 2024). Moreover, even though micro, these plastics are causing huge damage to the environment.
-
Disrupting ecosystem - When you rinse off a product the microplastics in them usually get flushed with water and accumulate in water bodies, posing a threat to marine life (Mehn & Odessa, 2020, #).
-
Harming body - Recent studies point out microplastics being found in fetal tissue, breast milk, and even newborns. Since microplastics are so tiny, they can slip past the body's natural filters and possibly damage different organs.
-
Skin damage - They can disrupt the skin's natural barrier and cause inflammation or irritation to the skin.
The presence of microplastics in skin and beauty care products is alarming. However, awareness around it is growing (thanks to people like us on the internet;). Many developed countries have already banned products containing microplastics and are developing laws to tackle the situation. Moreover, consumers today demand and support sustainable products, forcing industry giants to work on their formulations.
Change no matter how tiny it is makes a difference and plastic no matter how MICRO it is, is harmful to us and the environment.
References
Carrington, D. (2024, February 27). Microplastics found in every human placenta tested in study. The Guardian. Retrieved July 4, 2024, from https://www.theguardian.com/environment/2024/feb/27/microplastics-found-every-human-placenta-tested-study-health-impact
Guide to Microplastics - Check Your Products. (n.d.). Beat the Microbead. Retrieved July 4, 2024, from https://www.beatthemicrobead.org/guide-to-microplastics/
Mehn, A., & Odessa, V. (2020). Plastic In Skincare Cosmetics. International Journal of Applied Research in Management and Economics, 3(3), 17-29. ISSN 2538-8053
Microplastics - ECHA. (n.d.). ECHA. Retrieved July 4, 2024, from https://echa.europa.eu/hot-topics/microplastics
van Wering, D. (2022, April 30). PLASTIC - The hidden beauty ingredient. Beat the Microbead. Retrieved July 3, 2024, from https://www.beatthemicrobead.org/wp-content/uploads/2022/06/Plastic-TheHiddenBeautyIngredients.pdf